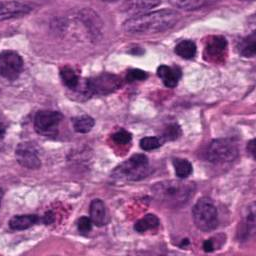
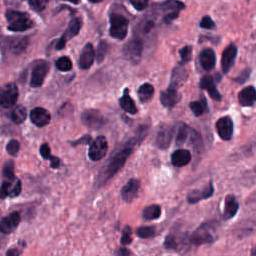
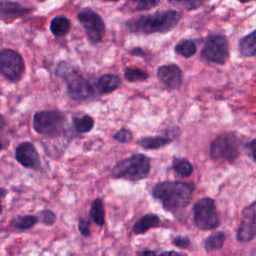

Histopathology image synthesis aims to address the data shortage issue in training deep learning approaches for accurate cancer detection. However, existing methods struggle to produce realistic images that have accurate nuclei boundaries and less artifacts, which limits the application in downstream tasks. To address the challenges, we propose a novel approach that enhances the quality of synthetic images by using nuclei topology and contour regularization. The proposed approach uses the skeleton map of nuclei to integrate nuclei topology and separate touching nuclei. In the loss function, we propose two new contour regularization terms that enhance the contrast between contour and non-contour pixels and increase the similarity between contour pixels. We evaluate the proposed approach on the two datasets using image quality metrics and a downstream task (nuclei segmentation). The proposed approach outperforms Sharp-GAN in all four image quality metrics on two datasets. By integrating 6k synthetic images from the proposed approach into training, a nuclei segmentation model achieves the state-of-the-art segmentation performance on TNBC dataset and its detection quality (DQ), segmentation quality (SQ), panoptic quality (PQ), and aggregated Jaccard index (AJI) is 0.855, 0.863, 0.691, and 0.683, respectively.
翻译:生理病理学图像合成旨在解决在为准确癌症检测而培训深层学习方法中的数据短缺问题;然而,现有方法力求产生具有准确核界限和较少人工制品的现实图像,从而限制下游任务的应用;为了应对挑战,我们提议了一种新办法,通过使用核表层学和等离谱法来提高合成图像的质量;拟议办法利用核心骨架图将核心表层和单独触摸核心整合为一体;在损失功能中,我们提议了两个新的等离子正规化术语,以加强等离子和不相接平流平流线之间的对比,并增加相近性;我们利用图像质量指标和下游任务(核分解)来评估两个数据集的拟议办法的质量质量;拟议办法在两个数据集的所有四个图像质量指标中均优于Sharp-GAN。通过将拟议方法中的6k合成图像纳入培训,一个核心分解模式,使等离子与非相近不一比,并增加相近的相像项;我们评估了两个数据集的拟议方法(0.83、0.85C质量和0.258质量)的状态分析业绩。